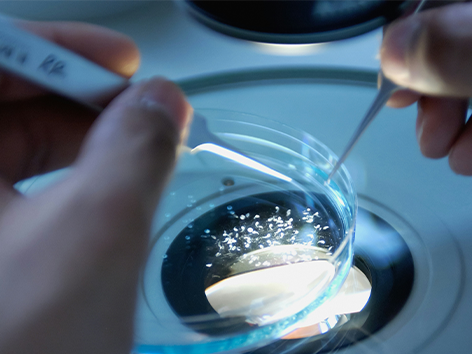

版权所有 © 山东大学郭卫华课题组 鲁ICP备案 05001952号

课程负责人:郭卫华上课时间:3面向对象:研究生授课教师:郭卫华开课学年:2023-2024开课学期:春学期课程号:0240051学分:2.0课程类型:研究生课程是否精品课程:否课时:32.0

课程负责人:郭卫华上课时间:3面向对象:研究生授课教师:郭卫华开课学年:2022-2023开课学期:春学期课程号:0240051学分:2.0课程类型:研究生课程是否精品课程:否课时:32.0

课程负责人:郭卫华上课时间:3面向对象:研究生授课教师:郭卫华开课学年:2021-2022开课学期:春学期课程号:0240051学分:2.0课程类型:研究生课程是否精品课程:否课时:32.0

课程负责人:郭卫华面向对象:本科生授课教师:郭卫华开课学年:2021-2022开课学期:春学期课程号:sd01433010学分:2.0课程类型:本科生课程是否精品课程:否课时:32.0

课程负责人:郭卫华面向对象:本科生授课教师:郭卫华开课学年:2021-2022开课学期:春学期课程号:sd01431370学分:1.0课程类型:本科生课程是否精品课程:否课时:16.0

我们培育了132个具有两种植物多样性水平的植物群落,并与基于10个全球变化因子(氮沉降、土壤盐渍化、干旱、植物入侵、模拟放牧、石油污染、塑料污染、抗生素污染、重金属污染和农药污染)的处理方案进行交叉。

我们培育了132个具有两种植物多样性水平的植物群落,并与基于10个全球变化因子(氮沉降、土壤盐渍化、干旱、植物入侵、模拟放牧、石油污染、塑料污染、抗生素污染、重金属污染和农药污染)的处理方案进行交叉。
课程负责人:郭卫华上课时间:5面向对象:研究生授课教师:郭卫华开课学年:2020-2021开课学期:春学期课程号:0240051学分:2.0课程类型:研究生课程是否精品课程:否课时:32.0

我们培育了132个具有两种植物多样性水平的植物群落,并与基于10个全球变化因子(氮沉降、土壤盐渍化、干旱、植物入侵、模拟放牧、石油污染、塑料污染、抗生素污染、重金属污染和农药污染)的处理方案进行交叉。